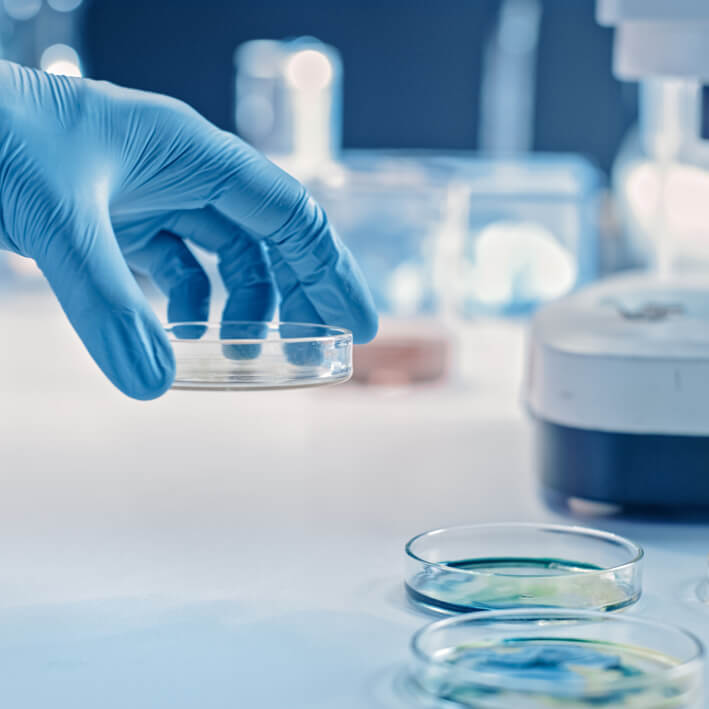

Hygiene Inspektion nach VDI 6022 / Hygienereinigung von Lüftungsanlagen
Bei unserer Hygieneinspektion gemäß VDI 6022 überprüfen wir die Luftqualität sowie die hygienischen Bedingungen Ihrer Lüftungs- und Klimaanlagen. Bei der Hygienereinigung von Lüftungsanlagen sorgen wir dafür, dass diese gründlich gereinigt und hygienisch einwandfrei sind.
Hygiene Inspektion nach VDI 6022
Im Rahmen unserer Hygieneinspektion gemäß VDI 6022 überprüfen wir die Luftqualität und die hygienischen Bedingungen Ihrer Lüftungs- und Klimaanlagen. Diese Inspektion umfasst nicht nur eine umfassende Analyse der Anlagenteile, sondern auch die Probennahme an der Lüftung. Die entnommenen Proben werden anschließend im Labor ausgewertet, um sicherzustellen, dass alle Komponenten den aktuellen Hygieneanforderungen entsprechen.
Unser qualifiziertes Team identifiziert potenzielle Risiken und gibt Ihnen Empfehlungen zur Optimierung der Hygiene in Ihren Systemen. Durch regelmäßige Inspektionen tragen wir dazu bei, die Gesundheit und das Wohlbefinden der Nutzer zu gewährleisten und die Effizienz Ihrer Anlagen zu steigern.
Wenn Sie Anpassungen oder spezifische Informationen benötigen, lassen Sie es uns wissen!
Hygienereinigung von Lüftungsanlagen
Für eine optimale Luftqualität und ein gesundes Raumklima ist die regelmäßige Lüftungs- und Hygienereinigung unerlässlich. Unser professioneller Service sorgt dafür, dass Ihre Lüftungsanlagen gründlich gereinigt und hygienisch einwandfrei sind.
Durch die Ansammlung von Staub, Schmutz und Mikroorganismen in den Lüftungskanälen können nicht nur die Effizienz Ihrer Anlagen beeinträchtigt werden, sondern auch die Gesundheit der Nutzer gefährdet sein. Unser erfahrenes Team führt eine umfassende Reinigung Ihrer Lüftungsanlagen durch und entfernt alle Verunreinigungen, um die Luftqualität zu verbessern. Wir verwenden moderne Reinigungsmittel, die eine gründliche und schonende Reinigung gewährleisten. Alle Arbeiten werden gemäß den geltenden Hygiene- und Sicherheitsstandards durchgeführt. So können Sie sicher sein, dass Ihre Lüftungsanlagen nicht nur effizient arbeiten, sondern auch ein gesundes Raumklima fördern.



